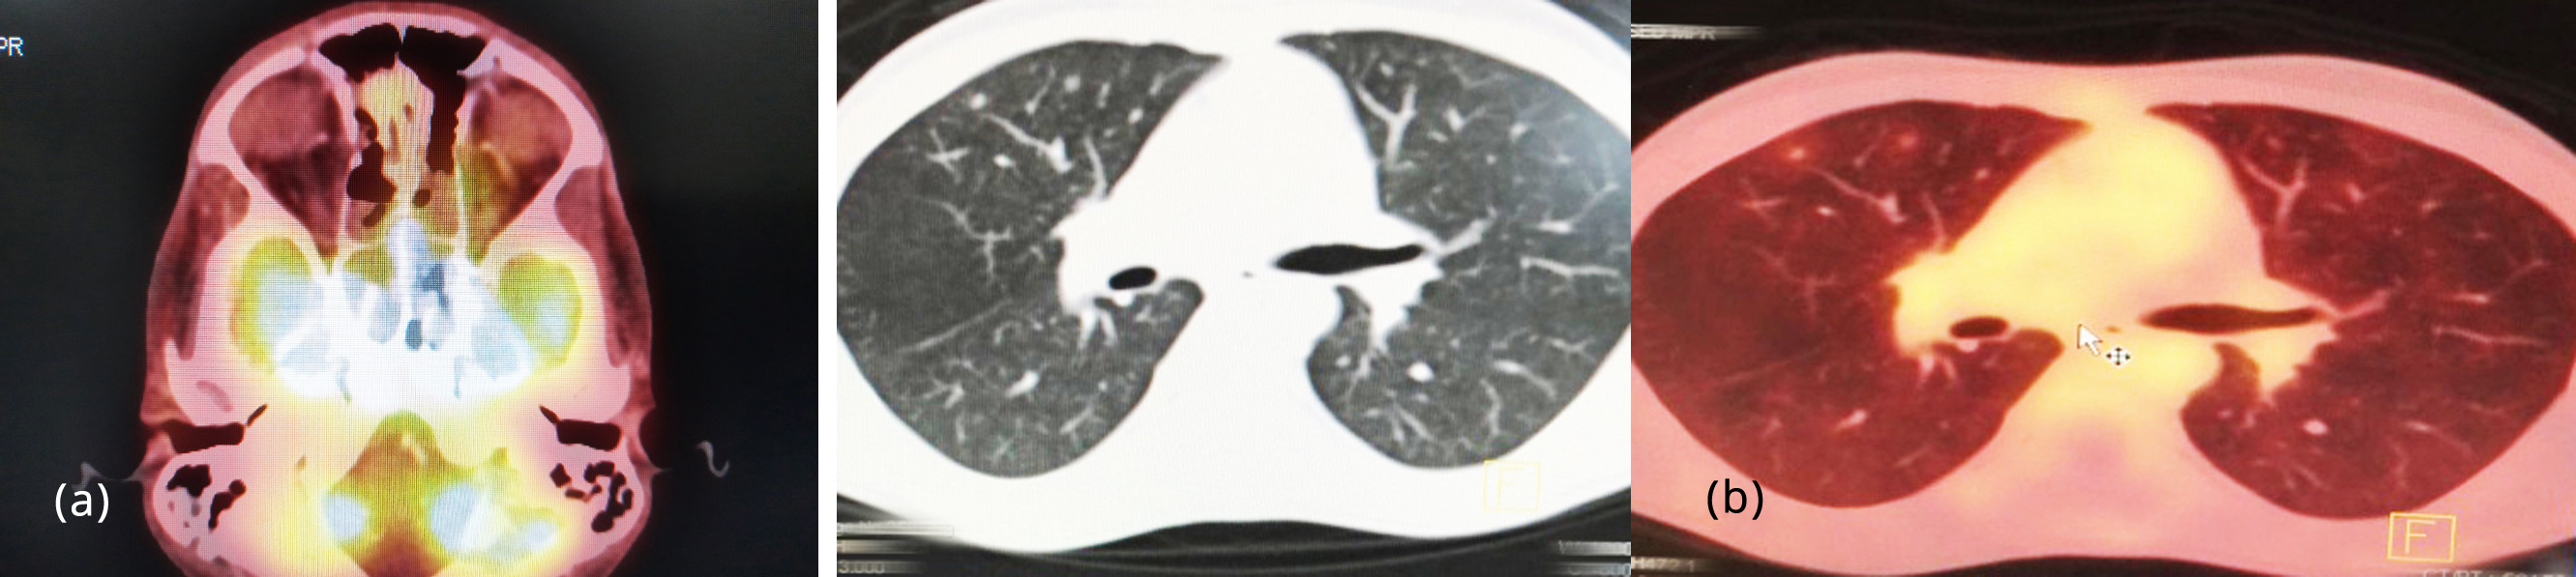
JMSR

Lytic Lesion Pet/ct
Discover cutting-edge Lytic Lesion Pet/ct through comprehensive galleries of modern photographs. showcasing contemporary approaches to photography, images, and pictures. designed to showcase innovation and progress. The Lytic Lesion Pet/ct collection maintains consistent quality standards across all images. Suitable for various applications including web design, social media, personal projects, and digital content creation All Lytic Lesion Pet/ct images are available in high resolution with professional-grade quality, optimized for both digital and print applications, and include comprehensive metadata for easy organization and usage. Explore the versatility of our Lytic Lesion Pet/ct collection for various creative and professional projects. Comprehensive tagging systems facilitate quick discovery of relevant Lytic Lesion Pet/ct content. The Lytic Lesion Pet/ct collection represents years of careful curation and professional standards. Diverse style options within the Lytic Lesion Pet/ct collection suit various aesthetic preferences. Professional licensing options accommodate both commercial and educational usage requirements. Reliable customer support ensures smooth experience throughout the Lytic Lesion Pet/ct selection process. The Lytic Lesion Pet/ct archive serves professionals, educators, and creatives across diverse industries. Time-saving browsing features help users locate ideal Lytic Lesion Pet/ct images quickly. Our Lytic Lesion Pet/ct database continuously expands with fresh, relevant content from skilled photographers.






![PET/CT scan with [18F] -fluorodeoxyglucose of hypermetabolic lytic ...](https://www.researchgate.net/publication/274644011/figure/fig1/AS:282627459305480@1444395045131/PET-CT-scan-with-18F-fluorodeoxyglucose-of-hypermetabolic-lytic-vertebral-lesions.png)

































































![[Figure, Lytic Lesion. The radiograph of...] - StatPearls - NCBI Bookshelf](https://www.ncbi.nlm.nih.gov/books/NBK559229/bin/GCT__Preop.jpg)

![[Table/Fig-1]:](https://www.jcdr.net/articles/images/11040/jcdr-12-ED01-g001.jpg)








